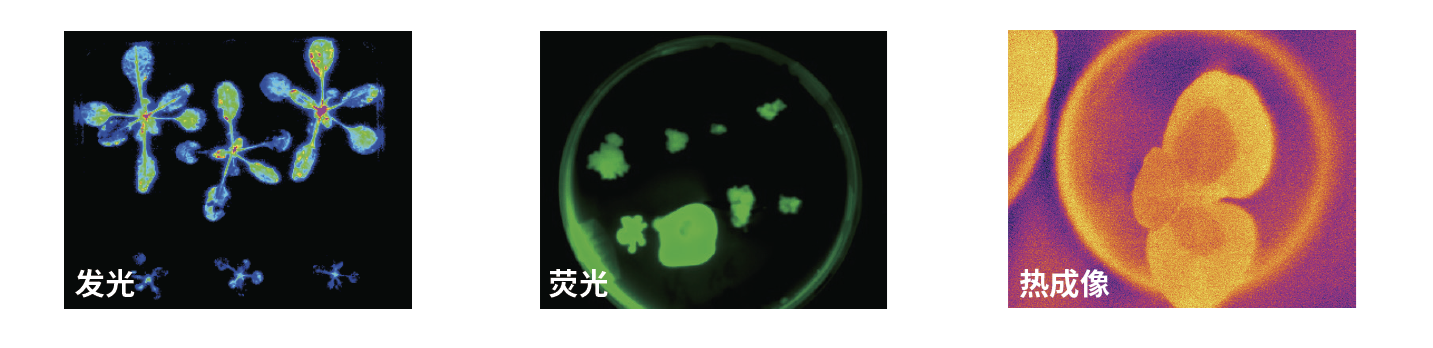
BioMerk

BioVIST 多功能植物活体成像仪
BioVIST是一个高灵敏的活体成像检测设备,具有发光荧光成像以及热成像功能,可以拍摄植物整体的发光和荧光信号以及温度信号。其暗箱具有温度控制模块,支持温度控制调节,超大的暗箱体积可以充分满足各种植株的生长观察需求。其也具有多种LED光源,可用于模拟日光系统,结合植物培养控制系统以及表型观察模块,可让研究人员直接观察监控活体植物的蛋白和基因表达,检测活体植物体内细菌侵染发展过程等。

产品特点
- BioVIST 全密闭的暗箱设计可保证样本在成像过程中处于绝对黑暗密闭的环境,屏蔽各种射线干扰,提高检测数据图像质量。成像暗箱使用双层设计双层保温,双层间具有15mm 厚度保温材料,保证箱体内温度控制效果。暗箱内提供植物生长需要的光照、温度等环境条件,由软件操作控制设置。
- 顶部和侧置成像系统配备了科研级深度制冷CCD 相机,具有科研级CCD 芯片,具备更高的光量子敏感性及量子转化率;多级珀耳帖半导体制冷系统,确保极低的背景噪音,实现超高检测灵敏度,可在长时间曝光条件下采集信号,达到无背景噪音的检测结果。
- 系统还配备了红外热成像相机,使用非制冷焦平面阵列检测器,热灵敏度可达到0.03℃,能够精确检测样品温度变化。可用于干旱胁迫研究、生物胁迫、品种筛选、表型研究等。
- BioVIST 独特的荧光光路设计,光激发光光源通过4 组光纤导光,激发光角度可在水平和垂直方向360 度自由调节,避免产生阴影。大功率连续激发波长,覆盖GFP、YFP、RFP 等多种报告基因,方便用户对不同的荧光标记进行检测实验。
- BioVIST 具备航空级别保温材料,可使整个暗室内部温度和湿度维持稳定。BioVIST 的暗箱内配备循环风温控系统,通过空气循环进行整体暗室环境控温控温控湿,可根据实验需要,对植物样本进行特定所需的高温或低温刺激,用于植物高温或低温胁迫研究。
- BioVIST 通过对均匀交叉分布的多色LED 光源,模拟不同时间下的真实日光的光谱及强度梯度;对样本进行全范围的光照培养。
- 为了进行植物的气体催化呼吸等方面的研究,BioVIST 具备气体控制系统,通过气体接口连接不同气瓶,软件根据箱体内置气体检测到的浓度值,自动控制气体输入,维持氧气、二氧化碳以及乙烯的特定浓度。
- 大尺寸电动样品台,较大样本也可直接放置在样品台上,一次即可完成多批次样品检测,节省实验时间。可配备高通量旋转台,一次可放置8 个培养皿,支持样品的垂直生长,进行高通量样品检测。可配备重力模块,支持按程序设定拍摄样本旋转固定角度进行向重背重性研究,亦可持续低速旋转扰乱重力方向,进行重力相关实验。